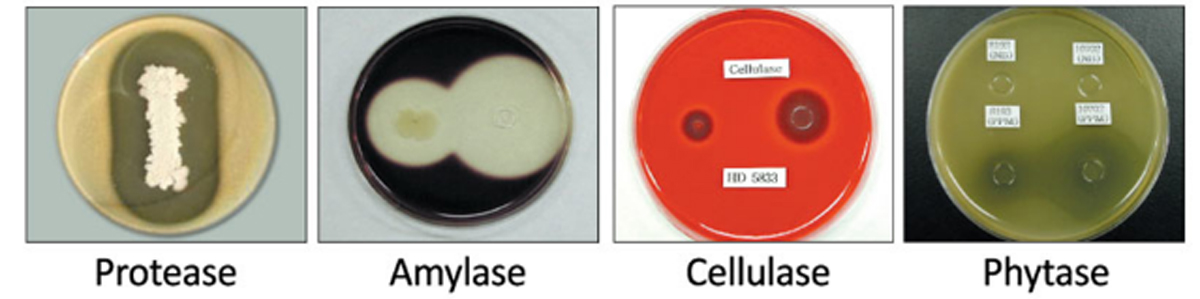

²úÆ·¼ò½é£º
ÓŸ£¿µÊDzÉÓÃÌØÊ⹤ÒÕɸѡ³öµÄº«¹ú»ùÔ´µÄÇ¿¿¹¾ú»îÐÔϵͳ΢ÉúÎïÓëøµÄ¸´ºÏÖÆ¼Á£¬º¬ÓÐ≥1.0×109cfu/gÒæÉú¾ú£¨¿Ý²ÝÑ¿æß¸Ë¾úHD8193¡¢5833¡¢8015¡¢3168ºÍ5442£©£¬¼°ÈéËá¾ú¡¢½Íĸ¾úµÈÌìȻ΢ÉúÎµ°°×ø¡¢µí·Ûø¡¢Ö¬·¾Ã¸¡¢°ëÏËÎ¬ËØÃ¸ºÍβ-°ëÈéÌÇÜÕøµÈ¡£
²úÆ·ÌØÐÔ£º
º«¹úרÀû¾úÖÖ£ºº¬ÓÐÊýÊ®Òڸߴ¿¶È¿Ý²ÝÑ¿æß¸Ë¾ú£¬¾ßÓг¬¸ß¸´»îÂÊ£¬ÔÚÌåÄÚÄܱ£´æ8¡«24Сʱ¸ß·±Ö³ÂÊ£»
¿¹Î¢ÉúÎï»îÐÔ£º·ÖÃÚϸ°û±ÚÁѽâø·Ö½âϸ¾úϸ°û±Ú£¬µ÷½Ú³¦µÀ¾úȺƽºâ
»·±££ºÏÔÖø½µµÍ°±Æø£¬¾»»¯ÇÝÉá»·¾³
·ÖÃÚÏû»¯Ã¸£ºÃ¸£ºµ°°×ø¡¢µí·Ûø¡¢°ëÏËÎ¬ËØÃ¸¡¢¿Ç¶àÌÇøµÈ
άÉúËØ¡¢¿¹¾úËØ£ºÎ¬ÉúËØÀࣺάÉúËØB¡¢K¡¢ÉúÎïËØ¡¢ÑÌõ£°·£»¿¹¾ú¼Á£º¸Ë¾úëÄ¡¢Õ³¾úËØ¡¢¿Ý²Ý¾úËØ
¿¹ÄæÐÔÇ¿µÄÑ¿æß£º¸ßÈÈÎȶ¨ÐÔ£¬¸ß´æ»îÂÊ£¬Ëá¼îÎȶ¨ÐÔ£ºÔÚpHÖµ´Ó1¡«12±ä»¯£¬½Ï¸ßµÄ´æ»îÂÊ
È«Ãæ»·¾³¸ÄÁ¼£ºÔöÇ¿³¦Î¸¹¦ÄÜ¡¢¼õÉÙ³¦µÀ¼²²¡¡¢Ìá¸ßËÇÁÏת»¯ÂÊ¡£¾»»¯ÌåÄÚÍâ»·¾³£¬½¨Á¢Á¼ºÃ΢Éú̬ϵͳ£¬Ìá¸ßÃâÒßÁ¦£¬¼õÉÙ·à±ãÅųöÁ¿£¬ÈܽâÓ¬Çù³æÂÑ£¬´ÓÔ´Í·½â¾öȦÉá¿ÕÆøÖÊÁ¿£¬½¨Á¢ÑøÖ³ÓѺû·¾³

ÓŸ£¿µÉúÎï¾úÄܽµµÍ³¦°±Å¨¶È£¬¸ÄÉÆ³¦µÀÄÚ»·¾³£¬¼õÉÙ¶¾ËزúÉú£»Äܵ÷½Ú¶¯Îï賦µÀ΢Éú̬»·¾³£¬µ÷Õû¾úȺƽºâ£¬ÐγÉÉúÎïÆÁÕÏÒÖÖÆÓк¦¾úµÄÉú³¤·±Ö³£¬´Ù½ø¶¯ÎïÉú³¤£¬´ïµ½Ìá¸ß¶¯ÎïÃâÒßÁ¦ºÍ½µµÍËÀÍöÂʵĹ¦Ð§

ÓŸ£¿µµÄÈÈÎȶ¨ÐÔ£º

182ÌåÓý¼¯ÍÅøµÄ»îÐÔ£º
182ÌåÓý¼¯ÍžßÓкÜÇ¿µÄ²úøÄÜÁ¦£ºµ°°×ø¡¢µí·Ûø¡¢ÏËÎ¬ËØÃ¸ºÍÖ²ËáøµÈ¡£
ÓŸ£¿µµÄÌåÍâ×÷Óãº
ÓŸ£¿µ¶ÔɳÃÅÊϾúÓкÜÇ¿µÄÒÖÖÆ×÷ÓÃ

182ÌåÓý¼¯ÍźͿ¹¾ú¼Á¼æÈÝÐÔµÄÌåÍâ²âÊÔ£º

ÓŸ£¿µÔÚ賦µÀµÄÎȶ¨ÐÔÊÔÑ飺

Ó÷¨ÓëÓÃÁ¿£º
ËÇÌí£ºÃ¿¶ÖËÇÁÏÌí¼ÓÓŸ£¿µ200¡«300¿Ë¡£
°ü×°¹æ¸ñ£º1kg*20°ü/Ïä¡¢20kg/´ü
ÓÐЧÆÚ£º2Äê
Ò»¡¢¹ã¶«6000Í·±£ÓýÖí2011Äê10Ô ÓŸ£¿µ¶Ô±ÈÊÔÑé½á¹û




¶þ¡¢ÓŸ£¿µÔÚĸÖíÉϵÄÓ¦ÓÃÊÔÑé
1.ÊÔÑé
1.1 ÊÔÑé²ÄÁÏ
ѡȡÅäÖÖʱ¼ä½Ó½ü¡¢Ì¥´Î´óÖÂÏàͬ¡¢½¡¿µ×´¿öÁ¼ºÃµÄ²úǰ5dµÄ¶þÔªÔÓ£¨³¤°×x¶ÅÂå¿Ë£©¾²úĸÖí26Í·¡£
ÓŸ£¿µÓÉÓÅĬÉúÎïÌṩ£¬Ìí¼Ó¼ÁÁ¿¸ù¾ÝÉú²ú³§¼Ò½¨ÒéÈ·¶¨¡£

1.2 ÊÔÑéÉè¼Æ
ÊÔÑéËæ»ú·ÖΪ2¸ö´¦Àí×飬ÿ¸ö´¦Àí×é13¸öÖØ¸´£¬Ã¿¸öÖØ¸´1ͷĸÖí¡£
¶ÔÕÕ×éËÇι²¸ÈéÆÚ»ù´¡ÈÕÁ¸£¬ÊÔÑé×éËÇι²¸ÈéÆÚ»ù´¡ÈÕÁ¸+ÓŸ£¿µ200g/t£¬²ú×Ð25dºóÊÔÑé½áÊø¡£
1.3 ËÇÑø¹ÜÀí
ÊÔÑéÓÚ2018Äê7.5-8.7£¨²úǰ5d-25dÈÕ¶ÏÄÌ£©Ôڹ㶫ijÉúÖíÑøÖ³»ùµØ¿ªÕ¹¡£
½øÐÐĸÖí·±Ö³ÐÔÄܼ°×ÐÖíÉú³¤ÐÔÄÜ¡¢²ÉʳÁ¿¡¢·à±ãÇé¿öµÈÏà¹ØÖ¸±êµÄ²â¶¨¡£
2.½á¹ûÓë½áÂÛ
2.1 ÓŸ£¿µ¶ÔĸÖí·±Ö³ÐÔÄܼ°×ÐÖíÉú³¤ÐÔÄܵÄÓ°Ïì

2.2 ÓŸ£¿µ¶ÔĸÖíÆ½¾ùÈÕ²ÉʳÁ¿µÄÓ°Ïì

2.3 182ÌåÓý¼¯ÍŶÔĸÖí·à±ãÐÎ̬¼°ÆÀ·ÖµÄÓ°Ïì

2.4 ½áÂÛ
ÔÚ·±Ö³Ä¸ÖíÖÐʹÓÃÓŸ£¿µ¶ÔĸÖí·±Ö³ÐÔÄÜÎÞÏÔÖøÓ°Ï죻
¼«ÏÔÖøÌá¸ß²úǰ5dµ½²ú×кó25dĸÖíµÄ²ÉʳÁ¿£»
Ã÷ÏÔ¸ÄɯďÖíµÄ·à±ãÐÎ̬£¬¼«ÏÔÖøÌá¸ß²¸ÈéĸÖí·à±ãÆÀ·Ö£¬½µµÍ±ãÃØ·¢ÉúÂÊ¡£
ÓŸ£¿µ
—— ÒæÉú¾ú¼°Ã¸¸´ºÏÖÆ¼Á
ÊÇÒ»ÖÖÌØÖÆµÄ΢ÉúÌ¬ÖÆ¼Á£¬Ò²ÊÇÒ»¸öÕë¶ÔÐÔµÄÒæÉúËØ£¬ÊÇά³Ö³¦µÀ¾úȺƽºâµÄÓÐÒæÎ¢ÉúÎï¡£

ÓŸ£ËØ£º
º«¹úÅݲËÖеÄÈé¸Ë¾ú¡¢Ã÷´®Çò¾ú¡¢ÎºË¹ÊϾú·¢½Í´úл²úÎïÌáÈ¡µÄÐÂÐÍÃâÒß¶àÌÇ¡¢¿¹Ñõ»¯ËáÐÔ¶àÌǵȳɷݣ¬µ÷½Ú¡¢Æ½ºâ³¦µÀ¾úȺµÈ¶àÑùÐÔÓÐÒæ¾ú¼°´úлÎïÐͬÓŸ£ËØ»îÐÔÎïÖÊ¿ìËÙ¼¤»î»úÌå×ÔÉíµÄÃâÒßʶ±ðºÍ¼à¹Ü£¬Í¬Ê±´ïµ½Ç¿Á¦µÖ¿¹³¦µÀÄÚÓк¦¾ú¡¢ÒÖÖÆºÍÇå³ý²¡¶¾µÈ¡£
ÓÅËá·Ê
—— ¸´ºÏÓлúËá¡¢¹û¹ÑÌÇ¡¢Ö²ÎᆱÓÍ¡¢Ã¹¾ú¶¾ËØÖж¾½â¶¾¼ÁµÈ

µ±Ç°Ä¸ÖíÑøÖ³ÉÏÃæÁٵij£¼ûÎÊÌâ
Ò»¡¢ÎÊÌâ¼°ÆäΣº¦
º«¹úÅݲËÖеÄÈé¸Ë¾ú¡¢Ã÷´®Çò¾ú¡¢ÎºË¹ÊϾú·¢½Í´úл²úÎïÌáÈ¡µÄÐÂÐÍÃâÒß¶àÌÇ¡¢¿¹Ñõ»¯ËáÐÔ¶àÌǵȳɷݣ¬µ÷½Ú¡¢Æ½ºâ³¦µÀ¾úȺµÈ¶àÑùÐÔÓÐÒæ¾ú¼°´úлÎïÐͬÓŸ£ËØ»îÐÔÎïÖÊ¿ìËÙ¼¤»î»úÌå×ÔÉíµÄÃâÒßʶ±ðºÍ¼à¹Ü£¬Í¬Ê±´ïµ½Ç¿Á¦µÖ¿¹³¦µÀÄÚÓк¦¾ú¡¢ÒÖÖÆºÍÇå³ý²¡¶¾µÈ¡£
1¡¢±ãÃØ
¢Ù²ÉʳϽµ¡¢Ó°ÏìÌ¥¶ù·¢Óý£»
¢ÚÃÚÈé²»×㣬ӰÏì×ÐÖíÉú³¤¡¢ÀÏ¡¡¢Ôö¼ÓËÀÍöÂÊ£»
¢ÛÖ±³¦¹ý¶àÎüÊÕ·à±ã¶¾ËØ£¬ÒýÆðÃâÒßϽµ¡¢Ôö¼Ó¼²²¡¸ÐȾÂÊ
2¡¢Ä¸ÖíÄÌË®²»×ãΣº¦
¢Ù×ÐÖí¸¹ÐºÔö¼Ó£»
¢ÚÄÌË®ÖÐĸԿ¹Ìå²»×㣻
¢Û×ÐÖí³Ô²»µ½³õÈéµ¼Ö¶öËÀ£¬ËÀÍöÂÊÌá¸ß£»
¢Ü×ÐÖíÉú³¤ÐÔÄÜϽµ
3¡¢²ú³Ì¹ý³¤Î£º¦
¢Ù²úËÀÌ¥(°×ËÀÌ¥)ÏÔÖøÔö¶à£¬Èõ×ÐÔö¶à£¬×ÐÖí³É»îÂÊϽµ£¬·¢²¡Âʸߣ¬¶ÏÄÌÎÑÖØÏ½µ£»
¢Úµ¼ÖÂĸÖíÌåÄÜÏûºÄ¹ý´ó£¬¹ý¶ÈÆ£ÀÍ£¬³öÏÖ²úºóÑáʳ¡¢²»³Ô¡¢Ä¸Öí²úºóÉÙÈé¡¢ÎÞÈ飬ĸÖíÄÌË®ÖÊÁ¿²î£¬×ÐÖí¸¹Ðº£¬´óС²»¾ùÔÈ£»
¢Ûµ¼Ö¶ñ¶²»¾¡¡¢Ó°Ïì×Ó¹¬±ÚµÄ»Ö¸´£¬×îÖÕÐγÉ×Ó¹¬Ñ×Ö¢£¬Ëõ¶ÌĸÖíÉú²úÄêÏÞ£»
¢Üµ¼Ö¶ÏÄ̺óĸÖíÅäÖÖÂʵ͡¢·µÇéÔö¶à¡£
¶þ¡¢ÎÊÌâ½â¾ö;¾¶——“ÈýÓÅ·½°¸”
ÓŸ£ËØ1kg/t +ÓŸ£¿µ200g/t(»³ÔÐ90ÌìÓÃÖÁ¶ÏÄÌ)
ÓÅËá·Ê1kg/t+ÓŸ£¿µ300g/t(»³ÔÐ90ÌìÓÃÖÁ¶ÏÄÌ)
“ÈýÓÅ·½°¸”ĸÖí±£½¡ÁÙ´²Ð§¹û£º
¢Ù¼õÉÙ±ãÃØ¡¢´Ù½ø²Éʳ£¬Ëõ¶Ì²ú³Ì£»
¢Ú´Ù½øÃÚÈ飬Ìá¸ß¶ÏÄÌ×ÐÖíÌåÖØ£»
¢Û½µµÍ·µÇ飬Ìá¸ßÅäÖÖÂÊ£»
¢Ü¼õÉÙÀ¶¶ú¡¢Ô²»·µÈ·±Ö³Õϰ¼²²¡µÄ¸ÐȾѹÁ¦£¬Ìá¸ßĸÖí½¡¿µÃâÒßÁ¦¡£

µ±Ç°×ÐÖíÑøÖ³ÃæÁÙµÄÖ÷ÒªÎÊÌâ
Ò»¡¢ÎÊÌâ¼°ÆäΣº¦
1¡¢³õÉúÖØµÍ£º×Ó¹¬ÄÚ·¢Óý³Ù»ºÊÇÓÉÓÚÓªÑøÓë¼¤ËØ²»×ãÒýÆðÈÑÉïÆÚÅßÌ¥ºÍÌ¥¶ùÆ÷¹Ù·¢Óý³Ù»º£¬´ÓĸÌåÏòÌ¥¶ùתÔ˵ÄÑø·ÖºÍÑõÆø²»×ã»á½µµÍÌ¥¶ùµÄÉú³¤ËÙ¶È£¬´Ó¶øÒýÆð×ÐÖí³õÉúÖØµÍ¼°²¹³¥Éú³¤Ç±Á¦µÍ£»
2¡¢¿¹²¡Á¦Èõ£ºÐÂÉú×ÐÖíÏû»¯Æ÷¹Ù²»·¢´ï£¬ÃâÒß¹¦Äܲ»ÍêÉÆ£¬È±·¦ÏÈÌìÐÔÃâÒßÁ¦£¬¿¹²¡Á¦Èõ£»
3¡¢¸¹ÐºÂʸߣºÖí³¡²¡¶¾¡¢Ï¸¾ú¸ÐȾѹÁ¦´ó£¬×ÐÖíÃâÒßÁ¦µÍ£¬Ñǽ¡¿µ±ÈÀý¸ß£¬×ÐÖí¸¹ÐºÂʸ߷¢£¬ËÀÌÔÂʾӸ߲»Ï¡£
¶þ¡¢ÎÊÌâ½â¾ö
±£ÓýǰÆÚ£¨2-3ÖÜ£©£ºÓŸ£ËØ2kg/T+ÓŸ£¿µ300g/T, Àû¶à°²±£ÓýǰÆÚ1-2ml/Ìì/Í·ÓÃ10Ì죻
±£ÓýÆÚ£ºÓŸ£ËØ2kg/t+ÓŸ£¿µ300g/t+ÓÅËá·Ê1kg/t
Èý¡¢“ÈýÓÅ·½°¸”×ÐÖí±£½¡ÁÙ´²Ð§¹û
¢Ù½¨Á¢³¦µÀÓÅÊÆ¾úȺ£¬´Ù½ø³¦µÀ½¡¿µ£¬½µµÍ¸¹ÐºÂÊ£»
¢ÚǿЧ¿¹²¡¶¾£¬ÌáÉý»úÌåÃâÒßÁ¦£¬½µµÍËÀÌÔÂÊ£»
¢Û¼õÉÙÈõ×У¬Ìá¸ßÉú³¤ËÙ¶È £»
¢ÜÌáÉý»úÌåÃâÒßÁ¦¡£
